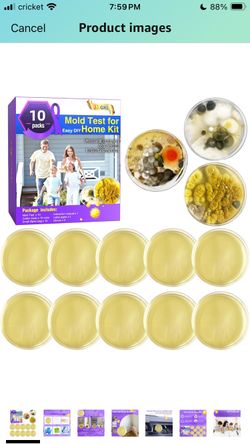

Seller profile
Zex
Joined Jan 2025
San Diego, CA
(4) offer up reviews
Seller statistics
1
Bought
5
Sold
1
Followers
Badges
- Confirmed phone
- Confirmed email
Compliments
- 3 Item as described compliments
- 3 Friendly compliments
- 2 On time compliments
- 2 Communicative compliments
- 2 Reliable compliments
Items from this seller
 New False Eyelash Kit – Includes Lashes, Applicator & Brush$5San Diego, CA
New False Eyelash Kit – Includes Lashes, Applicator & Brush$5San Diego, CA Piano Shaped Music Jewelry Box$5San Diego, CA
Piano Shaped Music Jewelry Box$5San Diego, CA Dog Teeth Cleaning Powder 100g Fights Plaque & Tartar Freshens Breath All-Natural Ingredients for Dogs of All Breeds and Ages Easy to Use Dog Dental P$5San Diego, CA
Dog Teeth Cleaning Powder 100g Fights Plaque & Tartar Freshens Breath All-Natural Ingredients for Dogs of All Breeds and Ages Easy to Use Dog Dental P$5San Diego, CA 2-in-1 Mini Curling Iron, 2025 Upgrade Dual Use Curling Iron Portable Travel Curler Flat Straightener for Women Short Hair All Hair Types (Green)$5San Diego, CA
2-in-1 Mini Curling Iron, 2025 Upgrade Dual Use Curling Iron Portable Travel Curler Flat Straightener for Women Short Hair All Hair Types (Green)$5San Diego, CA Cordless Hair Straightener Brush 3 in 1,Cordless Rechargeable Hair Straightener Comb Clip 5000mAh,Portable Travel Straightener,Mini Hot Straightening $20San Diego, CA
Cordless Hair Straightener Brush 3 in 1,Cordless Rechargeable Hair Straightener Comb Clip 5000mAh,Portable Travel Straightener,Mini Hot Straightening $20San Diego, CA African Net Sponge Authentic Bath Mesh Sponge, Deep Cleansing, Perfect for Back and Full Body Use Household Smooth Foam Brush (Violet,Coffee,Blue)$5San Diego, CA
African Net Sponge Authentic Bath Mesh Sponge, Deep Cleansing, Perfect for Back and Full Body Use Household Smooth Foam Brush (Violet,Coffee,Blue)$5San Diego, CA Mold Test for Home Kit$10San Diego, CA
Mold Test for Home Kit$10San Diego, CA Donald Trump Lives Here Stamp, Self Inking for 2024 Merchandise, Rubber Red Ink Stamp for Business Office Supplies$1San Diego, CA
Donald Trump Lives Here Stamp, Self Inking for 2024 Merchandise, Rubber Red Ink Stamp for Business Office Supplies$1San Diego, CA Candle Warmer Lamp with Timer Dimmer, Mothers Day Birthday Gifts for Mom Women Friend Sister, House Warming Gifts New Home Decor, Wax Melt Warmer with$10San Diego, CA
Candle Warmer Lamp with Timer Dimmer, Mothers Day Birthday Gifts for Mom Women Friend Sister, House Warming Gifts New Home Decor, Wax Melt Warmer with$10San Diego, CA Eyelash Growth Serum Volumizing Lash Serum For Eyelash Growth Longer & Thicker Lash Enhancing Serum With Natural Formula Vegan & Cruelty-Free (5 mL)$5San Diego, CA
Eyelash Growth Serum Volumizing Lash Serum For Eyelash Growth Longer & Thicker Lash Enhancing Serum With Natural Formula Vegan & Cruelty-Free (5 mL)$5San Diego, CA Kitchen Sink $5San Diego, CA
Kitchen Sink $5San Diego, CA Hydration Bladder$10San Diego, CA
Hydration Bladder$10San Diego, CA 6IN1Pet Hair Remover Tool$10San Diego, CA
6IN1Pet Hair Remover Tool$10San Diego, CA